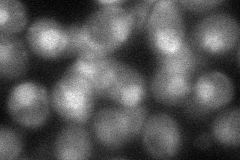

View description
Essential, non-ATPase regulatory subunit of the 26S proteasome, similar to another S. cerevisiae regulatory subunit, Rpn5p, as well as to mammalian proteasome subunits
Localization:
Intensity:
Fold change:
Significance:
-
C’ GFP library in SD

below threshold15.32 -
N' NOP1pr-GFP in SD

cytosol,nucleolus207.994 -
N' TEF2pr-mCherry in SD

nucleus129.48 -
N' NATIVEpr-GFP in SD

nucleus87.1774 -
N' TEF2pr-VC and Cyto-VN in SD
nucleus55.5626 -
C’ GFP library in SD+DTT

cytosol17.331.13No -
C’ GFP library in SD+H2O2

cytosol17.251.12No -
C’ GFP library in Starvation Media

cytosol13.540.88No -
C’ GFP library on the background of Pup2-DaMP

below threshold -
C’ GFP library on the background of CCT mutant

below threshold17.68831.15399No
